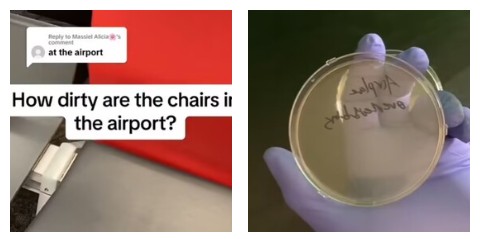
Quanto sono sporche le sedie di un aeroporto? Il video che le analizza diventa virale su TikTok: “Tenetelo a mente se volete fare un sonnellino qui”

Possiamo dire di esserne sorpresi? No. Eppure il video postato su TikTok dalla creator @howdirtyis è diventato virale. Cosa mostra? Intanto, siamo all’aeroporto La Guardia di New York e l’oggetto di interesse sono le sedie. Quelle sedie sulle quali quasi chiunque ha bivaccato in attesa di una coincidenza, o spazientito per un volo in ritardo o solo per un attimo di relax. Ebbene, la tiktoker prende un tampone e lo passa ovunque, sulla seduta, sullo schienale, sui braccioli. Il campione viene poi trasferito in una piastra di Petri, che viene messa in frigo in attesa che i risultati diventino visibili e analizzabili. “Abbastanza tosto, ma sembrano principalmente batteri della pelle. Diciamo che è una informazione da tenere a mente se volete mettervi qui e fare un pisolino”, la conclusione.
Insomma, le sedie in aeroporto non vengono pulite così spesso e sono talmente tante le persone che le usano da farle diventare ricettacoli di batteri. Con oltre 56.000 like, pur essendo qualcosa che ci si poteva aspettare, il filmato ha scatenato i commentatori: “L’aeroporto riesce sempre a farmi sentire sporco”, “Ecco perché mi cambio subito appena torno a casa”, e così via. Il dottor Darin Detwiler – ex FDA – ha dato al Daily Mail alcuni consigli per ridurre il rischio di esposizione ai germi durante i transiti aeroportuali: “L’esposizione inizia ben prima di entrare in aeroporto. Navette, taxi e servizi di rideshare sono spesso incubatori di malattie, con scarsa igienizzazione e ventilazione tra un passeggero e l’altro”. Per viaggiare in sicurezza, il medico consiglia di disinfettare con salviettine o gel igienizzante le superfici più a rischio, come le fibbie delle cinture di sicurezza o le maniglie delle portiere. E nelle lounge cambia qualcosa? “No, offrono un ambiente più tranquillo, ma non sono certo immuni alla contaminazione, soprattutto quando si tratta di buffet self-service e superfici toccate da tutti”.
@howdirtyis While waiting at the gate forever for your delayed flight, have you ever wondered how dirty the chair youre laying your head down on is? Lesseee #science #germ #sciencebiatch #gross #nasty #howdirtyis #dirty #interesting #bacteria #sciencetok #cool #fyp #clean #foryou #micro #curious #サイエンス #科学 #実験 #バクテリア #funfact #facts #fact #germs #interestingfact #interestingfacts #amazingfact #amazingfacts #amazing #randomfacts #randomfact #randomfactsforyou #factstime #dailyfact #funfacts #factoftheday #funfactoftheday #bio #biology #biomed #lab #labwork #cleantok#laboratorio #biologia #microbiologia #scitok #ScienceTok #scienceismagic #scienceiscool #sciencefair #foreigngerms #germsquad #mygerms #viral #bacterial #bacterialcontamination #petriedish #実験 #面白い #面白い動画 #viral #viralvideo #viraltiktok #trending w#trendingvideo #trendingtiktok #세균 #stem #stem #stemfeed #STEMfeed #longervideos #과학 #과학실험 #실험 #박테리아 #웃긴영상 #재미있는영상#scienceexperiment #scienceexperiments #experiment #learnontiktoktogether #travel #traveltiktok #traveltok #traveling ♬ Blame It on the Rain – Milli Vanilli